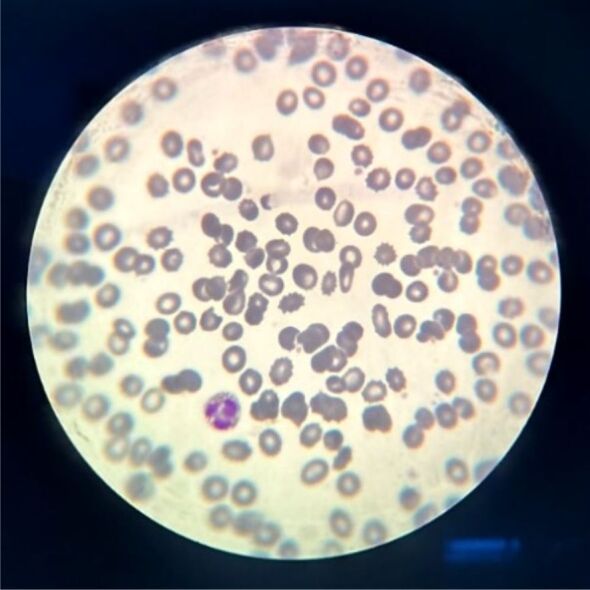
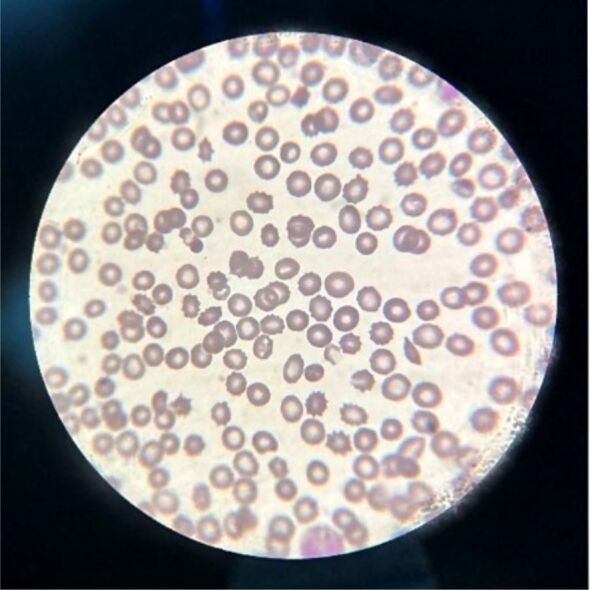

败血症对红细胞形态的影响:病例报告和文献综述。
IF 1.5
4区 医学
Q4 DEVELOPMENTAL BIOLOGY
引用次数: 0
摘要
本文重点介绍一例由软组织感染引起的败血症临床病例。对患者进行了外周血涂片、炎症生物标志物血浆值和白细胞计数检查。患者入院两天后,外周血涂片检查发现其形态发生了显著变化。患者在重症监护室(ICU)第三天后出现脓毒性休克。实验室结果显示,患者的形态发生了重大变化(红细胞变形、中性粒细胞异常);这些变化与白细胞介素-6 和降钙素原的血浆值升高有关。本文章由计算机程序翻译,如有差异,请以英文原文为准。

The influence of sepsis on erythrocytes morphology: case report and literature review.
This paper highlights a clinical case of sepsis caused by soft tissue infection. Peripheral blood smear, plasma value of inflammatory biomarkers and the white blood cells count were performed. Significant morphological changes were revealed through peripheral blood smear test two days after patient admission. Patient developed septic shock after the third day in intensive care unit (ICU). Laboratory results showed major morphological changes (erythrocytes deformity, abnormal neutrophils); these were correlated with elevated plasma value of interleukin-6 and procalcitonin.
求助全文
通过发布文献求助,成功后即可免费获取论文全文。
去求助
来源期刊

Romanian Journal of Morphology and Embryology
DEVELOPMENTAL BIOLOGY-
CiteScore
1.70
自引率
20.00%
发文量
221
审稿时长
3-8 weeks
期刊介绍:
Romanian Journal of Morphology and Embryology (Rom J Morphol Embryol) publishes studies on all aspects of normal morphology and human comparative and experimental pathology. The Journal accepts only researches that utilize modern investigation methods (studies of anatomy, pathology, cytopathology, immunohistochemistry, histochemistry, immunology, morphometry, molecular and cellular biology, electronic microscopy, etc.).
 求助内容:
求助内容: 应助结果提醒方式:
应助结果提醒方式:


